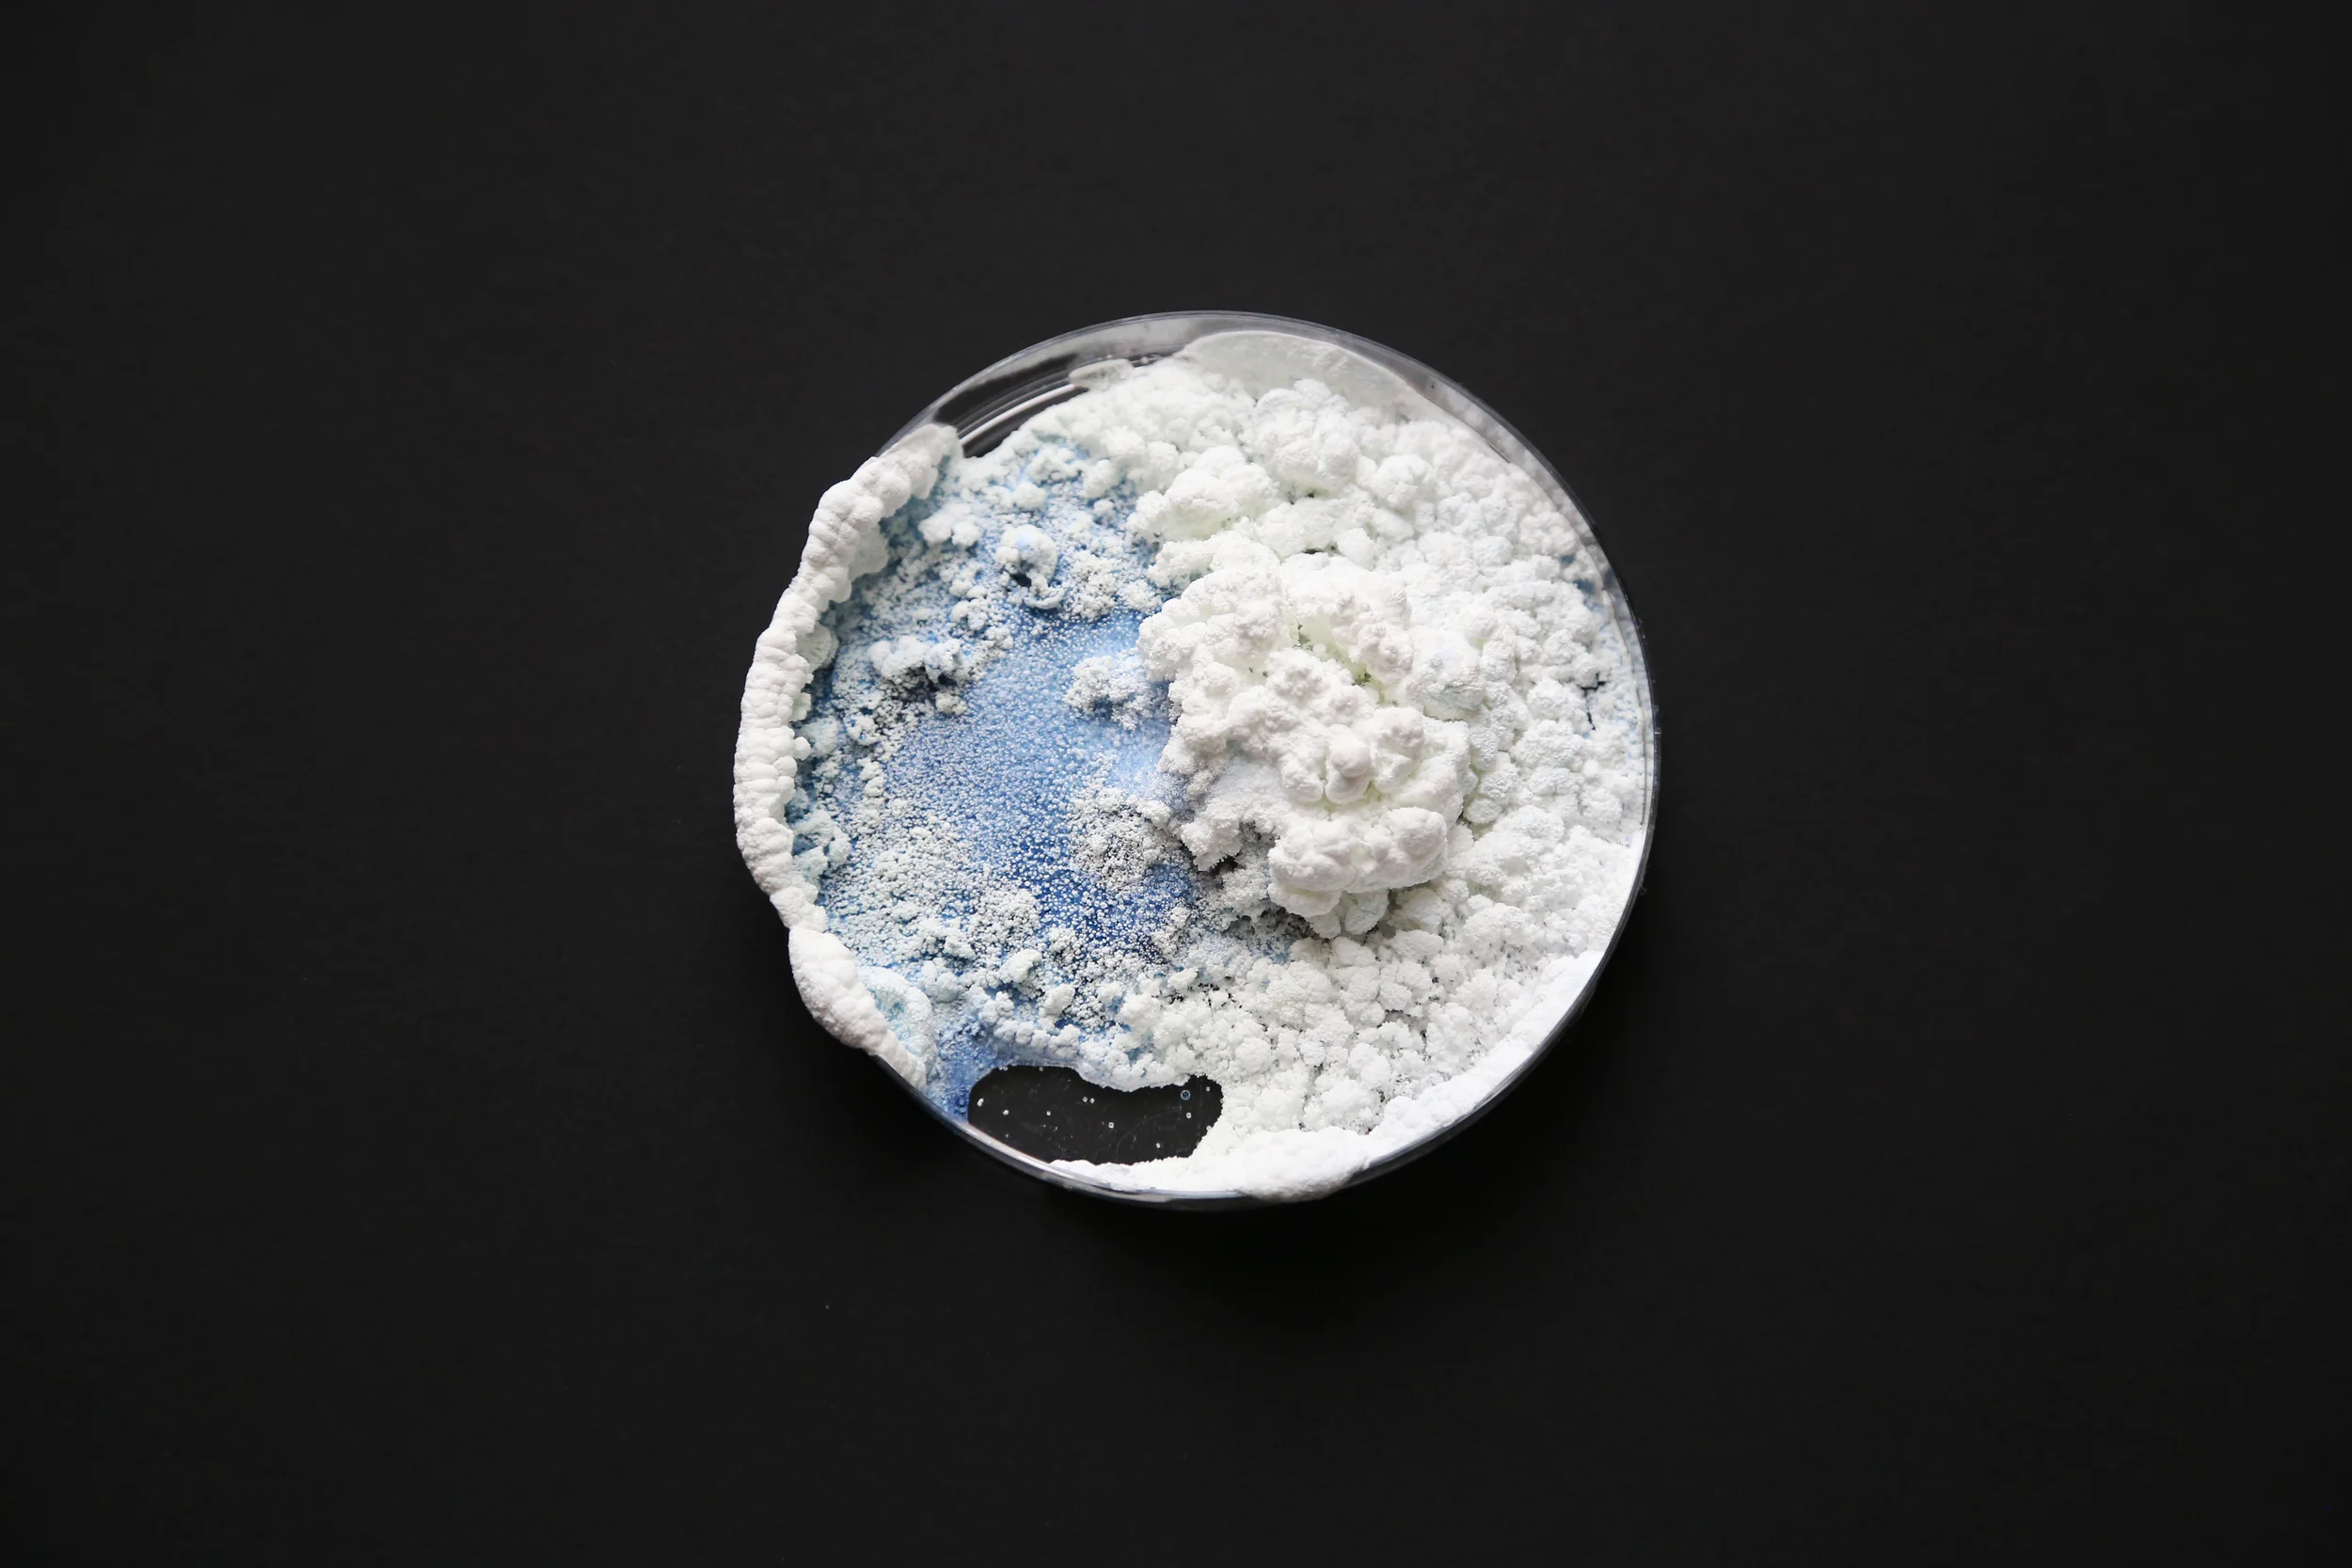
IMG_7763.JPG
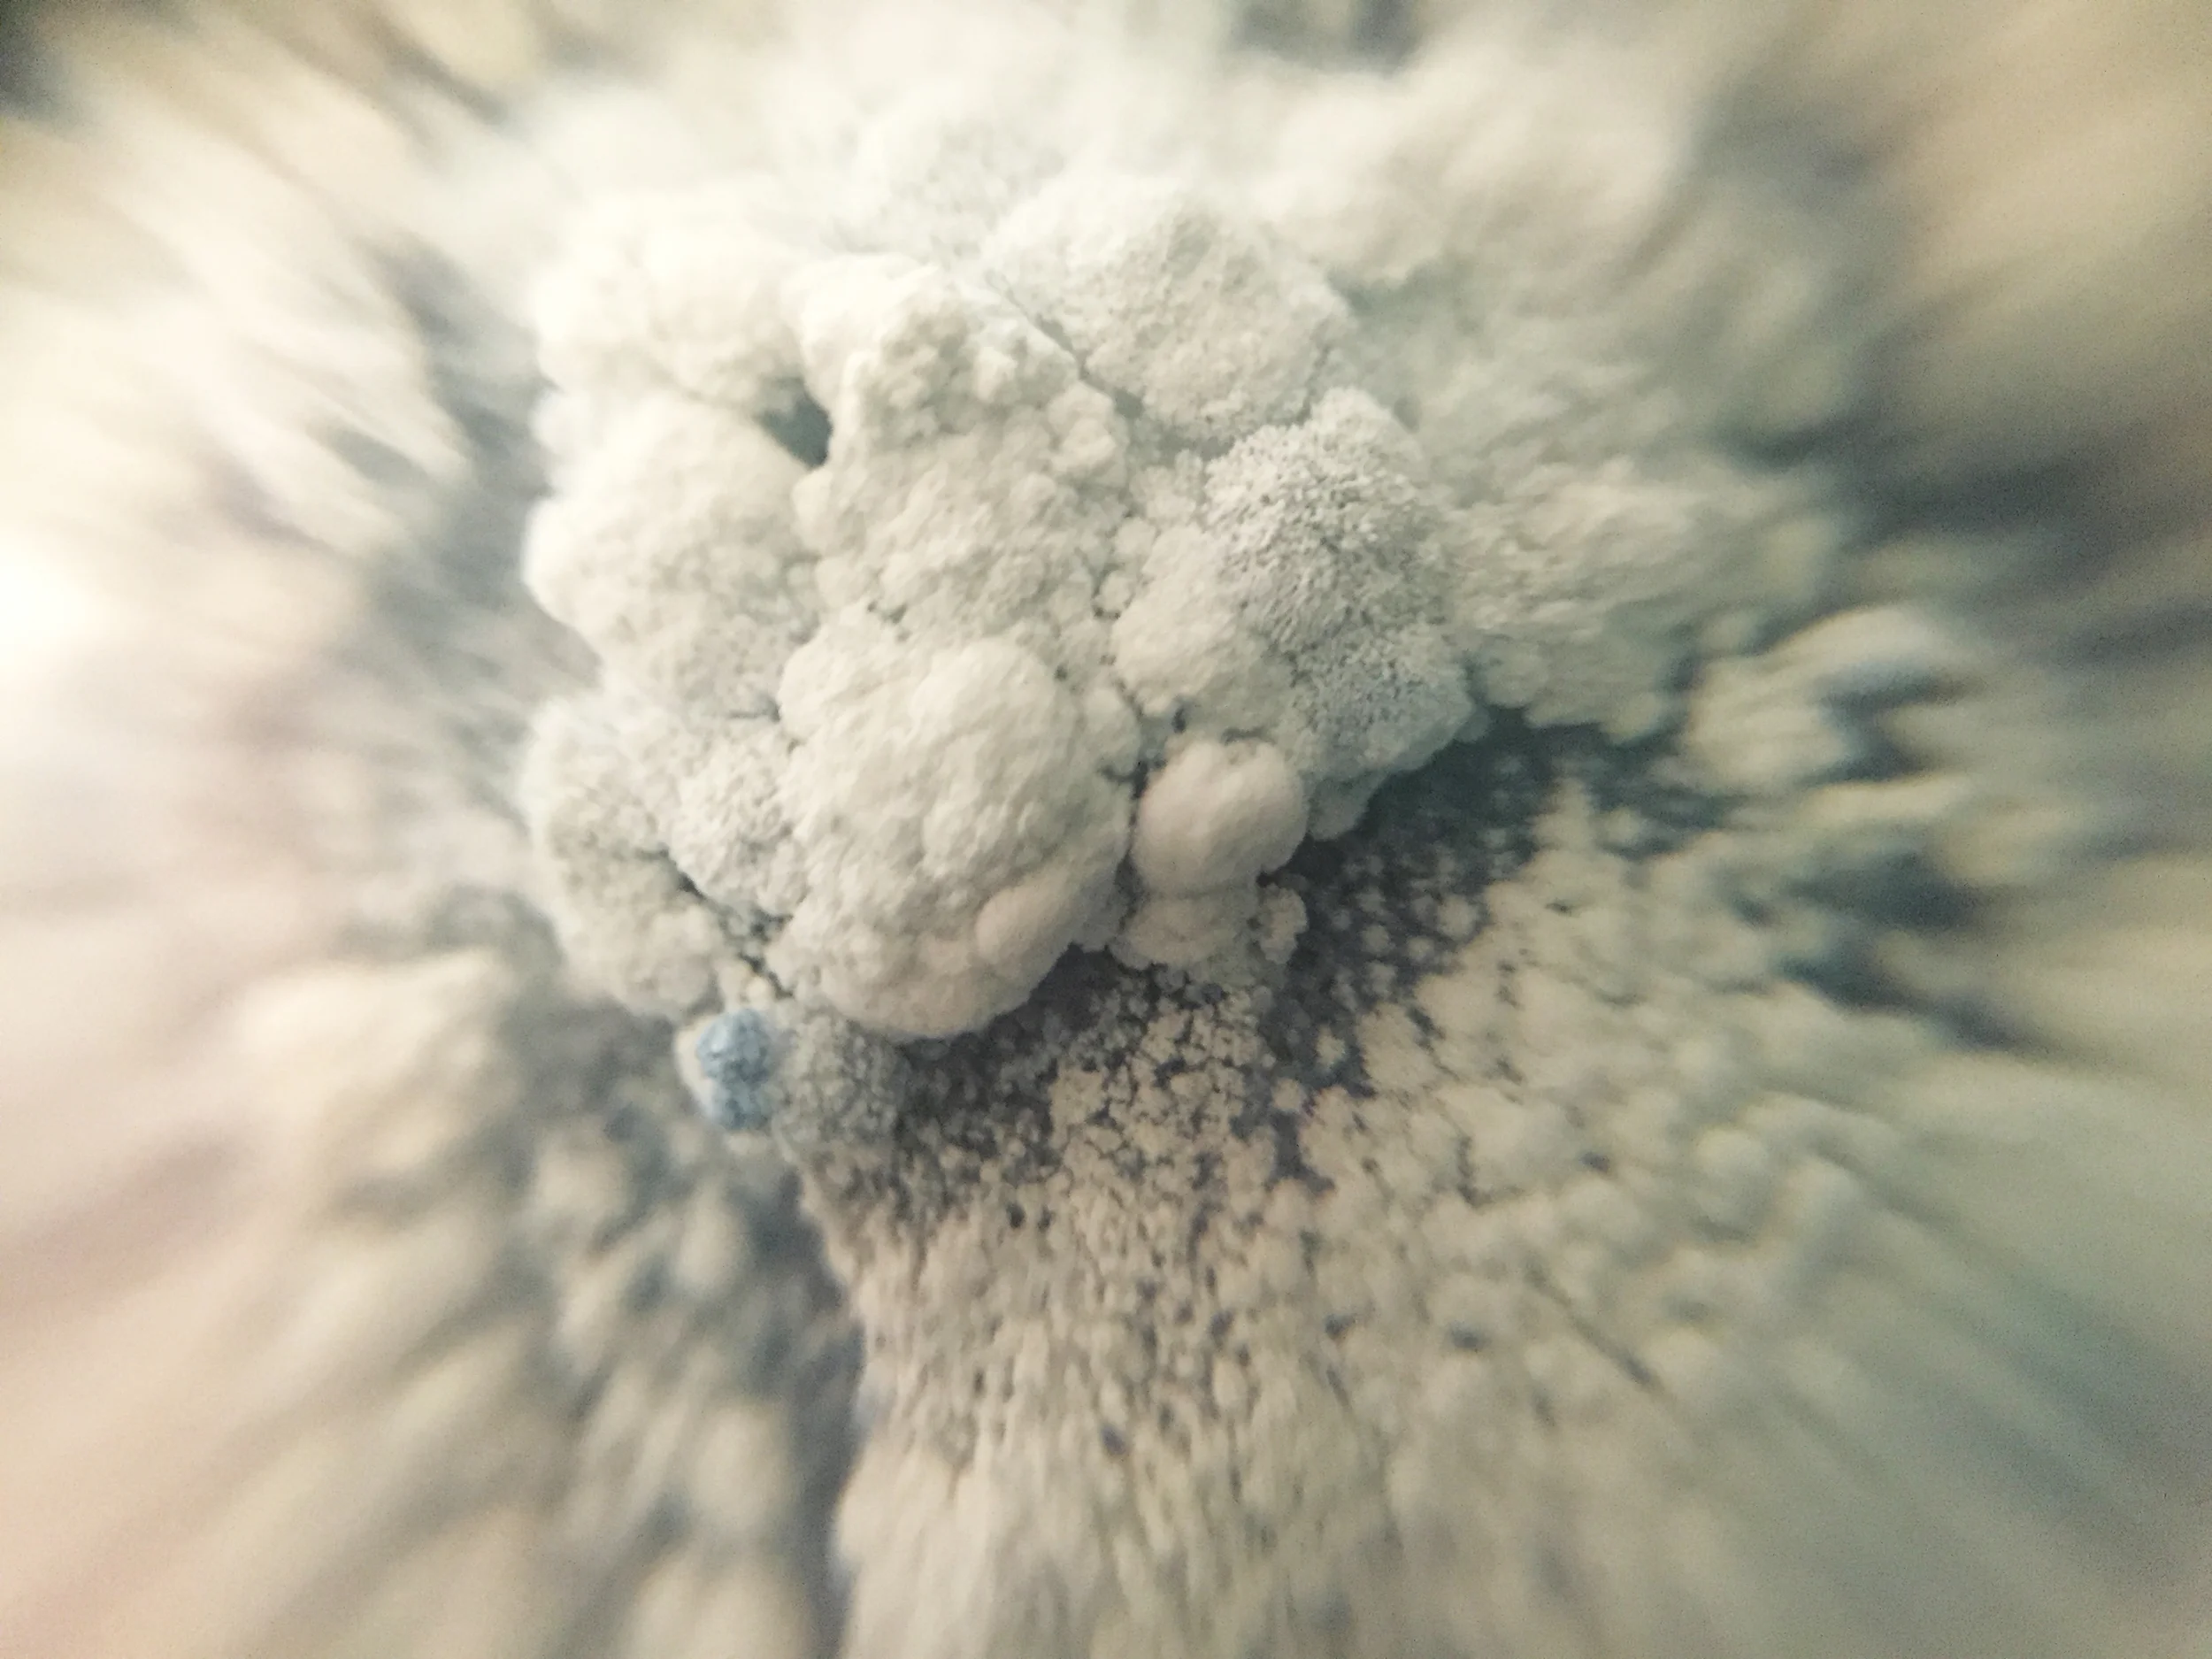
IMG_8035.JPG

A Site-specific performative installation
Site: Fort Adams, Newport RI
The following piece is a part of a group show of site responsive installations at historic Fort Adams located in Newport, RI. The show titled Fort Adams:Drawing Parallels, Listening for Echoes was a culmination of work completed during a semester long course at the Rhode Island School of Design.
Entering Fort Adams I sought a space that spoke to me, and more so a space that felt like it had not yet spoken to itself. Structure that does not understand nature and nature that does not care for structure. After visiting the site I began to draw, thinking about this connection and sorting out modes of understanding. Systematically planning, but at all moments considering a responsive approach to the environment. Searching for a connection to the fort and its location on the Narraganset Bay I watched the tops of sails pass by the towering walls blocking the horizon.
During this project I came into connection with many sail makers in Rhode Island who were gracious enough to donate out of commission sails to the project. Locally sourced materials, and particularly reuse of material was very important to this piece. I was interested in the history of it all and understanding material for just that, material.
Over the course of this projects installation the piece was twice "destroyed" by the harsh costal winter weather and wind. I did not go back to be beginning and attempt to fix or perfect the form but instead began to consider my want to be sensitive to nature. In many ways I wanted to retain control, but realized that in order for the piece to become what it needed to be I had to work intuitively and practice letting go.
A poem constructed through process, derived from notes on drawings below.
Crossbedding, a layer between
Referencing the undulation of the landscape
A steel structure to respond to
A wavelength turned into an environmental score
Layers fluttering together
Like something washed up from the sea
Rule is: needs to be connected at 3 points, water, wind, earth
To create volume
Drawing lines through space, for form to follow
Histories converging into a point
Wind driven waves on the sea
Billowing
Layers in time and space, capturing, holding
A transition zone
Mediating conversation and exchange
Creating an experience for the environment
To be present in the space and open to its sensibilities
Bring energy into the space, life, flow, materiality of the earth
Illustrate forces of weathering and erosion
You can see the ocean
A quiet place where the fort can meet the sea
And speak about their histories and futures
Erode histories, deposit truths, a layering of strata
Bursting outward, plunging into the ground
Exposing and exploring materiality
Sails from various times but one place
Bursts of energy, absorbed by the fort
Finding the space between
To the wall, to the sea
Nets to capture wind and time
A moment for the earth
A fabric folding and unfolding
A mesh of sensibilities
Remnants of sail language
Coexisting, crossing and connecting points
A woven structure system
Organic attachment, decided by a skeleton
A water informed landscape
To make the fort permeable to the ocean
To reveal the preservation of time and the inability to hold
Stretching through time and space
Sound and water
A non place
Wrapping and unravelling
An Undulation of waves
Passing of time
Material becomes more material